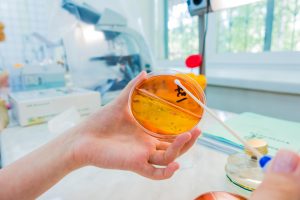
photo mains d'un scientifique manipulant des cellules

Retrouvez toute l’actualité de l’Arsla et de la lutte contre la SLA

Des éléments de réponse aux questions les plus fréquentes qui nous sont posées sur : le diagnostic, le traitement, le suivi de la maladie, la vie quotidienne, la prise en charge et les aides, la recherche, …
Le neurone est une des cellules composant le tissu nerveux avec les cellules gliales. Les neurones constituent l’unité fonctionnelle du système nerveux et les cellules gliales assurent le soutien et la nutrition des cellules nerveuses. Le système nerveux comprend environ cent milliards de neurones. Le neurone est une cellule dite polarisée avec des prolongements qui conduisent l’information et qui véhiculent les substances nécessaires au bon fonctionnement de la cellule. Les ‘dendrites’ sont des prolongements centripètes allant de la périphérie vers le corps cellulaire. Les axones sont centrifuges et vont du corps cellulaire vers la périphérie. La jonction entre l’axone d’une cellule et les dendrites d’une autre cellule est appelée synapse.
Le neurone moteur, également appelé « motoneurone », est une cellule nerveuse spécialisée dans la commande des mouvements. Il existe en fait deux grands types de neurones moteurs, le premier est dit central et se situe dans le cerveau, il achemine le message initial du cerveau jusque dans la moelle épinière. Le second, dit périphérique, débute dans la moelle épinière et achemine le message de la moelle épinière jusqu’aux muscles. Dans les atteintes des neurones moteurs, seules les fonctions motrices sont touchées, il n’existe donc pas de troubles sphinctériens, de troubles de la sensibilité, ni de troubles de l’intelligence.
Il n’y a pas de cause précise identifiée à l’heure actuelle. Il existe plusieurs hypothèses pour expliquer la dégénérescence du neurone moteur.
Certaines sont en faveur de facteurs environnementaux, d’autres des facteurs endogènes, c’est-à-dire de mécanismes internes produits par l’organisme Aucune étude n’a pour l’instant mis en évidence de mécanisme précis. Les études qui ont été menées jusqu’à présent étaient axées sur l’un ou l’autre facteur. Ces recherches n’ayant rien donné, des études sont menées pour déterminer s’il existe des facteurs croisés entre les facteurs environnementaux et endogènes.
En fonction du mode de début, on distingue : les formes bulbaires avec l’apparition en premier de troubles de la parole ou de la déglutition et les formes spinales (c’est-à-dire touchant la moelle épinière) avec une apparition initiale sur un des membres. Il existe des SLA dites monoméliques, qui ne touchent qu’un membre, et une variante est la paralysie bulbaire pure qui ne touche que la déglutition et la parole.